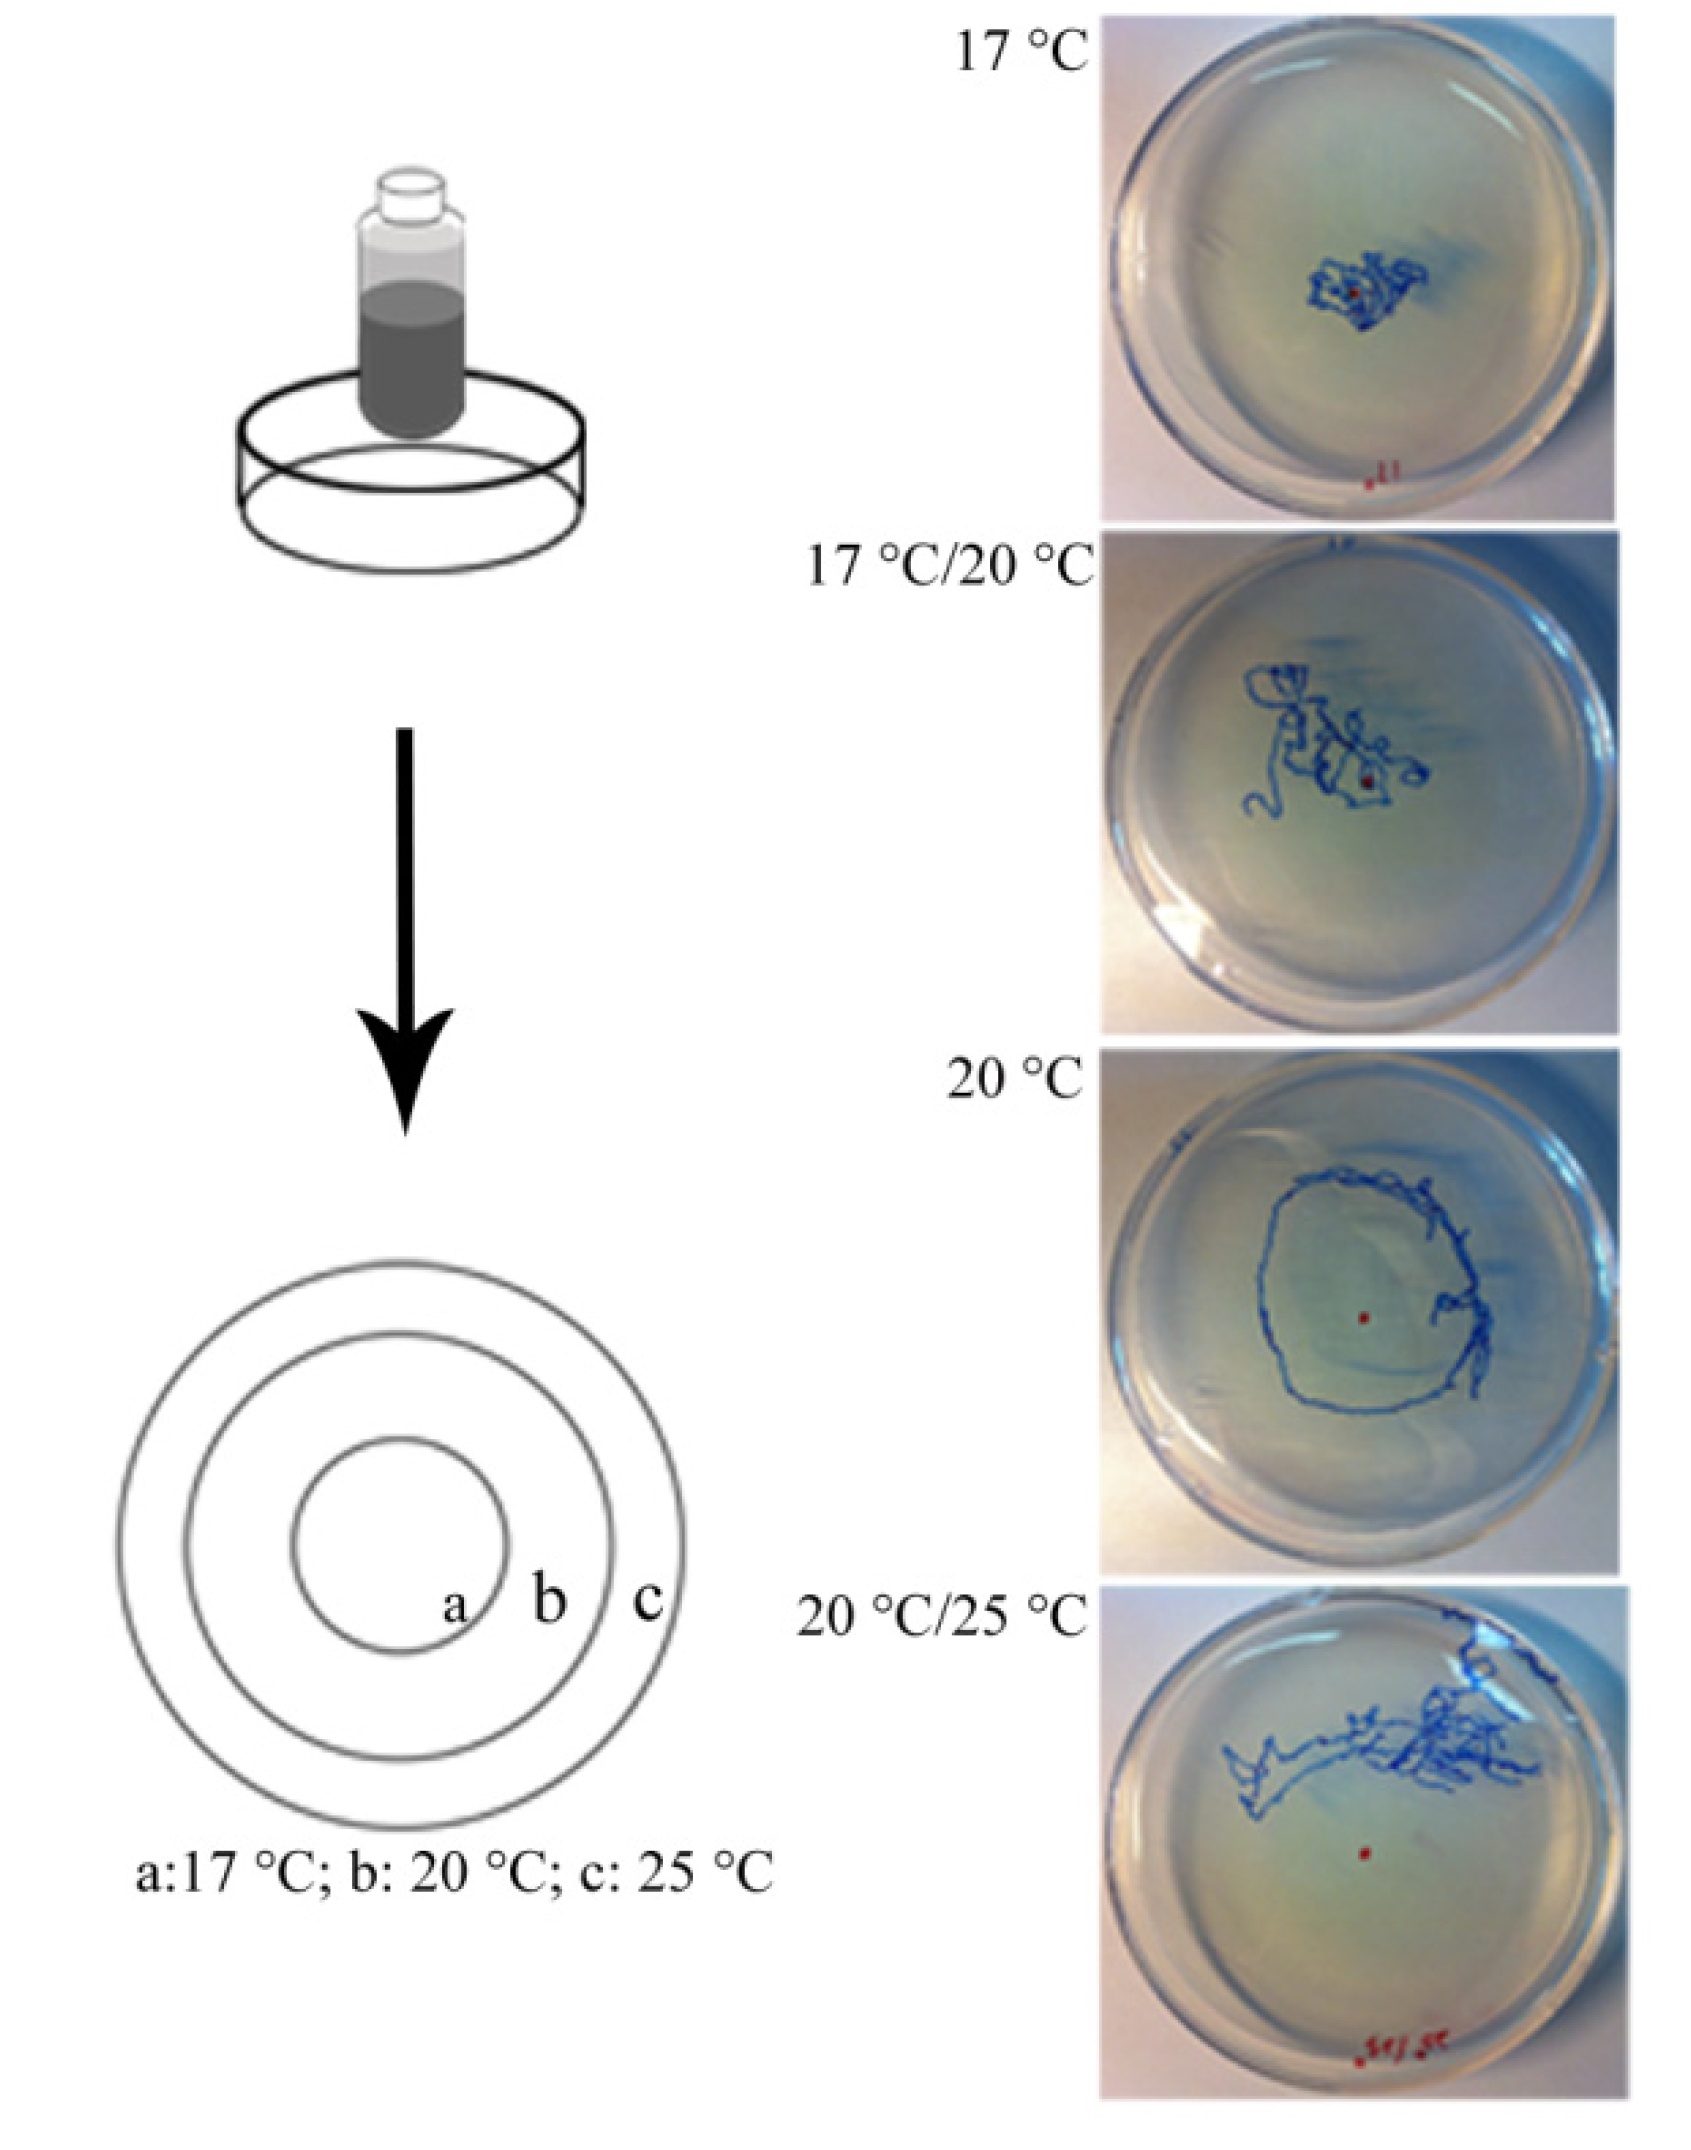
Ijerph 11 04589 g003 1024

Cyanobacterial Xenobiotics as Evaluated by a Caenorhabditis elegans Neurotoxicity Screening Test
Abstract
:1. Introduction
2. Experimental Section
2.1. Strains
2.2. Preparation of Plates and Exposure Conditions
| The Culture Filtrate | Microcystins, µg·L−1 |
|---|---|
| Microcystis aeruginosa batch culture | MC-RR 244 ± 7% |
| in Z-medium + 200 µg·L−1·Br | MC-YR 180 ± 11% |
| MC-LR 332 ± 3% |
2.3. Analysis of Microcystins in the Culture Filtrate
2.4. Locomotion Behavior
2.5. Pharyngeal Pumping
2.6. Defecation Assay

2.7. Chemotaxis Assay

2.8. Thermotaxis Assay
2.9. Mechanical Sensory Stimulus
3. Data Analysis
4. Results
4.1. Autonomic Function
4.2. Sensory Function






5. Discussion
5.1. Applicability of C. elegans as a Model for Neurotoxicity
5.2. Cyanotoxins and M. aeruginosa Culture Filtrate
6. Conclusions
Acknowledgments
Author Contributions
Conflicts of Interest
References
- Paerl, H.W.; Huisman, J. Climate: Blooms like it hot. Science 2008, 320, 57–58. [Google Scholar] [CrossRef]
- Welker, M.; von Döhren, H. Cyanobacterial peptides—Nature’s own combinatorial biosynthesis. FEMS Microbiol. Rev. 2006, 30, 530–563. [Google Scholar] [CrossRef]
- Mackintosh, C.; Beattie, K.A.; Klumpp, S.; Cohen, P.; Codd, G.A. Cyanobacterial microcystin-LR is a potent and specific inhibitor of protein phosphatases 1 and 2A from both mammals and higher plants. FEBS Lett. 1990, 264, 187–192. [Google Scholar] [CrossRef]
- Pouria, S.; de Andrade, A.; Barbosa, J.; Cavalcanti, R.L.; Barreto, V.T.S.; Ward, C.J.; Preiser, W.; Poon, G.K.; Neild, G.H.; Codd, G.A. Fatal microcystin intoxication in haemodialysis unit in Caruaru, Brazil. Lancet 1998, 352, 21–26. [Google Scholar] [CrossRef]
- Dittmann, E.; Wiegand, C. Cyanobacterial toxins—Occurrence, biosynthesis and impact on human affairs. Mol. Nutr. Food Res. 2006, 50, 7–17. [Google Scholar] [CrossRef]
- Park, H.-D.; Watanabe, M.F.; Harada, K.-I.; Nagai, H.; Suzuki, M.; Watanabe, M.; Hayashi, H. Hepatotoxin (microcystin) and neurotoxin (anatoxin-a) contained in natural blooms and strains of cyanobacteria from Japanese freshwaters. Nat. Toxins 1993, 1, 353–360. [Google Scholar] [CrossRef]
- Saul, N.; Chakrabarti, S.; Stürzenbaum, S.R.; Menzel, R.; Steinberg, C.E.W. Molecular insights into the toxicity mechanisms of microcystin-LR in Caenorhabditis elegans. Chem. Biol. Interact. 2014. accepted. [Google Scholar]
- Guidelines for Neurotoxicity Risk Assessment; Environmental Protection Agency: Washington, DC, USA, 1998.
- Leung, M.C.K.; Williams, P.L.; Benedetto, A.; Au, C.; Helmcke, K.J.; Aschner, M.; Meyer, J.N. Caenorhabditis elegans: An emerging model in biomedical and environmental toxicology. Toxicol. Sci. 2008, 106, 5–28. [Google Scholar]
- Kaletta, T.; Hengartner, M.O. Finding function in novel targets: C. elegans as a model organism. Nat. Rev. Drug Discov. 2006, 5, 387–398. [Google Scholar] [CrossRef]
- Anderson, G.L.; Cole, R.D.; Williams, P.L. Assessing behavioral toxicity with Caenorhabditis elegans. Environ. Toxicol. Chem. 2004, 23, 1235–1240. [Google Scholar]
- Anderson, G.L.; Boyd, W.A.; Williams, P.L. Assessment of sublethal endpoints for toxicity testing with the nematode Caenorhabditis elegans. Environ. Toxicol. Chem. 2001, 20, 833–838. [Google Scholar]
- Rajini, P.S.; Melstrom, P.; Williams, P.L. A comparative study on the relationship between various toxicological endpoints in Caenorhabditis elegans exposed to organophosphorus insecticides. J. Toxicol. Environ. Health Pt. A 2008, 71, 1043–1050. [Google Scholar]
- Dhawan, R.; Dusenbery, D.B.; Williams, P.L. Comparison of lethality, reproduction, and behavior as toxicological endpoints in the nematode Caenorhabditis elegans. J. Toxicol. Environ. Health Pt. A 1999, 58, 451–462. [Google Scholar]
- Boyd, W.A.; Anderson, G.L.; Dusenbery, D.B.; Williams, P.L. Computer Tracking Method for Assessing Behavioral Changes in the Nematode Caenorhabditis elegans. ASTM Spec. Tech. Publ. 2000, 9, 225–238. [Google Scholar]
- Melstrom, P.C.; Williams, P.L. Measuring movement to determine physiological roles of acetylcholinesterase classes in Caenorhabditis elegans. J. Nematol. 2007, 39, 317–320. [Google Scholar]
- Boyd, W.A.; Cole, R.D.; Anderson, G.L.; Williams, P.L. The effects of metals and food availability on the behavior of Caenorhabditis elegans. Environ. Toxicol. Chem. 2003, 22, 3049–3055. [Google Scholar]
- Jones, D.; Candido, E.P.M. Feeding is inhibited by sublethal concentrations of toxicants and by heat stress in the nematode Caenorhabditis elegans: Relationship to the cellular stress response. J. Exp. Zool. 1999, 284, 147–157. [Google Scholar]
- Dhawan, R.; Dusenbery, D.B.; Williams, P.L. A comparison of metal-induced lethality and behavioral responses in the nematode Caenorhabditis elegans. Environ. Toxicol. Chem. 2000, 19, 3061–3067. [Google Scholar]
- Cole, R.D.; Anderson, G.L.; Williams, P.L. The nematode Caenorhabditis elegans as a model of organophosphate-induced mammalian neurotoxicity. Toxicol. Appl. Pharmacol. 2004, 194, 248–256. [Google Scholar]
- Hunt, P.R.; Olejnik, N.; Sprando, R.L. Toxicity ranking of heavy metals with screening method using adult Caenorhabditis elegans and propidium iodide replicates toxicity ranking in rat. Food Chem. Toxicol. 2012, 50, 3280–3290. [Google Scholar]
- Hütteroth, A.; Putschew, A.; Jekel, M. Natural production of organic bromine compounds in Berlin lakes. Environ. Sci. Technol. 2007, 41, 3607–3612. [Google Scholar] [CrossRef]
- Li, Y.; Wang, Y.; Yin, L.; Pu, Y.; Wang, D. Using the nematode Caenorhabditis elegans as a model animal for assessing the toxicity induced by microcystin-LR. J. Environ. Sci. 2009, 21, 395–401. [Google Scholar] [CrossRef]
- Ju, J.; Ruan, Q.; Li, X.; Liu, R.; Li, Y.; Pu, Y.; Yin, L.; Wang, D. Neurotoxicological evaluation of microcystin-LR exposure at environmental relevant concentrations on nematode Caenorhabditis elegans. Envir. Sci. Pollut. Res. 2013, 20, 1823–1830. [Google Scholar] [CrossRef]
- Li, Y.; Ye, H.; Du, M.; Zhang, Y.; Ye, B.; Pu, Y.; Wang, D. Induction of chemotaxis to sodium chloride and diacetyl and thermotaxis defects by microcystin-LR exposure in nematode Caenorhabditis elegan. (in Chinese). J. Environ. Sci.-China 2009, 21, 971–979. [Google Scholar]
- Li, Y.H.; Wang, Y.; Yin, L.H.; Pu, Y.P.; Wang, D.Y. Using the nematode Caenorhabditis elegans as a model animal for assessing the toxicity induced by microcystin-LR. (in Chinese). J. Environ. Sci.-China 2009, 21, 395–401. [Google Scholar]
- Brenner, S. The genetics of Caenorhabditis elegans. Genetics 1974, 77, 71–94. [Google Scholar]
- Ju, J.; Lieke, T.; Saul, N.; Pu, Y.; Yin, L.; Cindy, K.; Anke, P.; Baberschke, N.; Steinberg, C.E.W. Neurotoxic evaluation of two organobromine model compounds and natural AOBr-containing surface water samples by a Caenorhabditis elegans test. Ecotoxicol. Environ. Safety 2014, 104, 194–201. [Google Scholar] [CrossRef]
- Mahoney, T.R.; Luo, S.; Round, E.K.; Brauner, M.; Gottschalk, A.; Thomas, J.H.; Nonet, M.L. Intestinal signaling to GABAergic neurons regulates a rhythmic behavior in Caenorhabditis elegans. Proc. Nat. Acad. Sci. USA 2008, 105, 16350–16355. [Google Scholar]
- Saeki, S.; Yamamoto, M.; Iino, Y. Plasticity of chemotaxis revealed by paired presentation of a chemoattractant and starvation in the nematode Caenorhabditis elegans. J. Exp. Biol. 2001, 204, 1757–1764. [Google Scholar]
- Kuhara, A.; Okumura, M.; Kimata, T.; Tanizawa, Y.; Takano, R.; Kimura, K.D.; Inada, H.; Matsumoto, K.; Mori, I. Temperature sensing by an olfactory neuron in a circuit controlling behavior of C. elegans. Science 2008, 320, 803–807. [Google Scholar] [CrossRef]
- Liedtke, W.; Tobin, D.M.; Bargmann, C.I.; Friedman, J.M. Mammalian TRPV4 (VR-OAC) directs behavioral responses to osmotic and mechanical stimuli in Caenorhabditis elegans. Proc. Nat. Acad. Sci. USA 2003, 100, 14531–14536. [Google Scholar] [CrossRef]
- Mirakhur, R.K. Comparative study of effects of oral and i.m. atropine and hyoscine in volunteers. Brit. J. Anaesth. 1978, 50, 591–598. [Google Scholar] [CrossRef]
- Hedgecock, E.M.; Russell, R.L. Normal and mutant thermotaxis in the nematode Caenorhabditis elegans. Proc. Nat. Acad. Sci. USA 1975, 72, 4061–4065. [Google Scholar] [CrossRef]
- Moser, V.C.; Phillips, P.M.; Levine, A.B.; Mcdaniel, K.L.; Sills, R.C.; Jortner, B.S.; Butt, M.T. Neurotoxicity produced by dibromoacetic acid in drinking water of rats. Toxicol. Sci. 2004, 79, 112–122. [Google Scholar] [CrossRef]
- Geary, T.G.; Sims, S.M.; Thomas, E.M.; Vanover, L.; Davis, J.P.; Winterrowd, C.A.; Klein, R.D.; Ho, N.F.H.; Thompson, D.P. Haemonchus contortus: Ivermectin-induced paralysis of the pharynx. Exp. Parasitol. 1993, 77, 88–96. [Google Scholar] [CrossRef]
- Sun, E.A.; Snape, W.J., Jr.; Cohen, S.; Renny, A. The role of opiate receptors and cholinergic neurons in the gastrocolonic response. Gastroenterology 1982, 82, 689–693. [Google Scholar]
- Lopachin, R.M. Acrylamide Neurotoxicity: Neurological, Morhological and Molecular Endpoints in Animal Models. In Advances in Experimental Medicine and Biology: Chemistry and Safety of Acrylamide in Food; Friedman, M., Mottram, D., Eds.; Springer: New York, NY, USA, 2005; Volume 561, pp. 21–37. [Google Scholar]
- Hasegawa, K.; Miwa, S.; Isomura, K.; Tsutsumiuchi, K.; Taniguchi, H.; Miwa, J. Acrylamide-responsive genes in the nematode Caenorhabditis elegans. Toxicol. Sci. 2008, 101, 215–225. [Google Scholar] [CrossRef]
- Bumke-Vogt, C.; Mailahn, W.; Chorus, I. Anatoxin-a and neurotoxic cyanobacteria in German lakes and reservoirs. Environ. Toxicol. 1999, 14, 117–125. [Google Scholar] [CrossRef]
- Welker, M.; von Döhren, H.; Täuscher, H.; Steinberg, C.E.W.; Erhard, M. Toxic Microcystis in shallow lake Müggelsee (Germany)—Dynamics, distribution, diversity. Arch. Hydrobiol. 2003, 157, 227–248. [Google Scholar] [CrossRef]
- Bell, S.G.; Codd, G.A. Cyanobacterial toxins and human health. Rev. Med. Microbiol. 1994, 5, 256–264. [Google Scholar]
- Barford, D. Molecular mechanisms of the protein serine/threonine phosphatases. Trends Biochem. Sci. 1996, 21, 407–412. [Google Scholar] [CrossRef]
- Baganz, D.; Staaks, G.; Steinberg, C. Impact of the cyanobacteria toxin, microcystin-LR on behaviour of zebrafish, Danio rerio. Water Res. 1998, 32, 948–952. [Google Scholar] [CrossRef]
- Fischer, W.J.; Altheimer, S.; Cattori, V.; Meier, P.J.; Dietrich, D.R.; Hagenbuch, B. Organic anion transporting polypeptides expressed in liver and brain mediate uptake of microcystin. Toxicol. Appl. Pharmacol. 2005, 203, 257–263. [Google Scholar]
- Cazenave, J.; Wunderlin, D.A.; Bistoni, M.D.L.A.; Amé, M.V.; Krause, E.; Pflugmacher, S.; Wiegand, C. Uptake, tissue distribution and accumulation of microcystin-RR in Corydoras paleatus, Jenynsia multidentata and Odontesthes bonariensis: A field and laboratory study. Aquat. Toxicol. 2005, 75, 178–190. [Google Scholar] [CrossRef]
- Mcintire, S.L.; Jorgensen, E.; Kaplan, J.; Horvitz, H.R. The GABAergic nervous system of Caenorhabditis elegans. Nature 1993, 364, 337–341. [Google Scholar] [CrossRef]
© 2014 by the authors; licensee MDPI, Basel, Switzerland. This article is an open access article distributed under the terms and conditions of the Creative Commons Attribution license (http://creativecommons.org/licenses/by/3.0/).
Share and Cite
Ju, J.; Saul, N.; Kochan, C.; Putschew, A.; Pu, Y.; Yin, L.; Steinberg, C.E.W. Cyanobacterial Xenobiotics as Evaluated by a Caenorhabditis elegans Neurotoxicity Screening Test. Int. J. Environ. Res. Public Health 2014, 11, 4589-4606. https://doi.org/10.3390/ijerph110504589
Ju J, Saul N, Kochan C, Putschew A, Pu Y, Yin L, Steinberg CEW. Cyanobacterial Xenobiotics as Evaluated by a Caenorhabditis elegans Neurotoxicity Screening Test. International Journal of Environmental Research and Public Health. 2014; 11(5):4589-4606. https://doi.org/10.3390/ijerph110504589
Chicago/Turabian StyleJu, Jingjuan, Nadine Saul, Cindy Kochan, Anke Putschew, Yuepu Pu, Lihong Yin, and Christian E. W. Steinberg. 2014. "Cyanobacterial Xenobiotics as Evaluated by a Caenorhabditis elegans Neurotoxicity Screening Test" International Journal of Environmental Research and Public Health 11, no. 5: 4589-4606. https://doi.org/10.3390/ijerph110504589
APA StyleJu, J., Saul, N., Kochan, C., Putschew, A., Pu, Y., Yin, L., & Steinberg, C. E. W. (2014). Cyanobacterial Xenobiotics as Evaluated by a Caenorhabditis elegans Neurotoxicity Screening Test. International Journal of Environmental Research and Public Health, 11(5), 4589-4606. https://doi.org/10.3390/ijerph110504589
